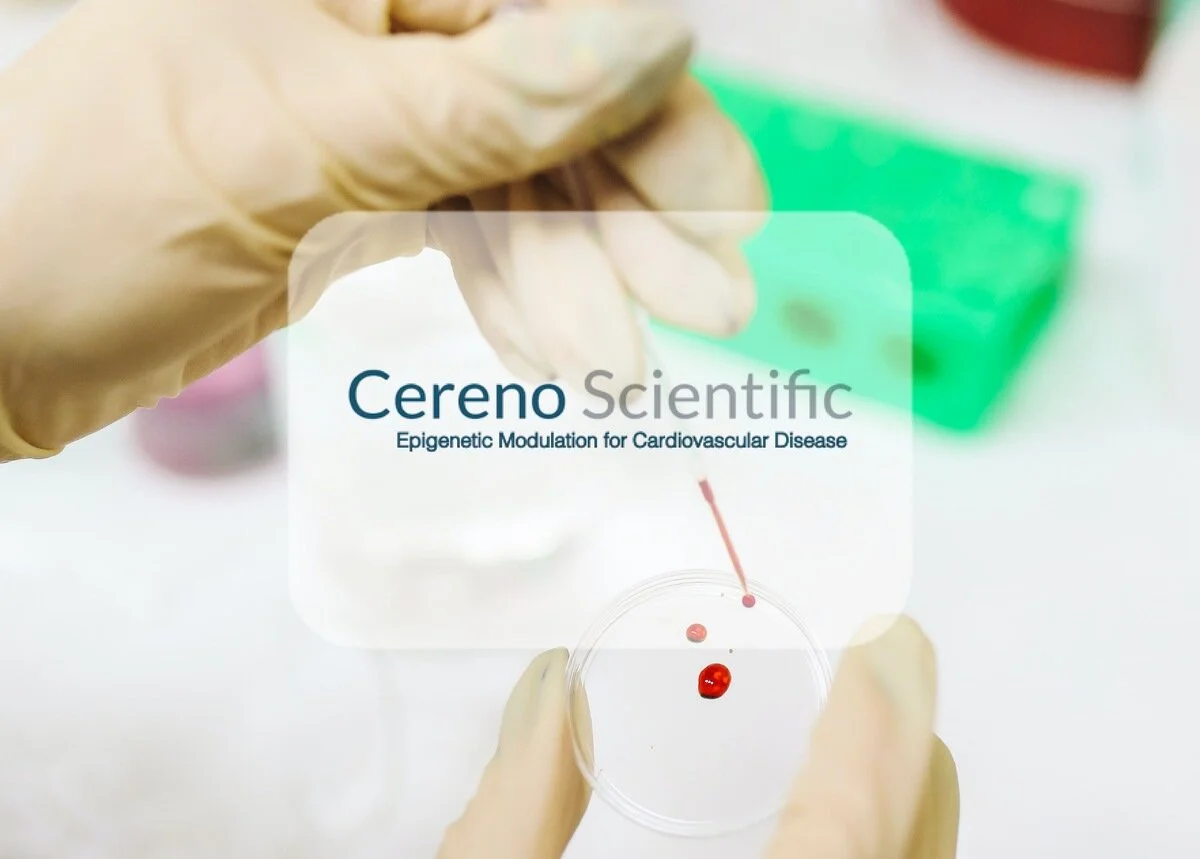
Cereno Scientific går in i nya området sällsynta sjukdomar med främsta läkemedelskandidaten CS1

Alzinova har mottagit positiv återkoppling efter vetenskaplig rådgivning som företaget erhållit från den finska läkemedelsmyndigheten, Fimea. Rådgivningen avsåg kliniska och regulatoriska aspekter av den fas 1b-studie med det terapeutiska vaccinet ALZ-101 som företaget avser att inleda på patienter med Alzheimers sjukdom i Finland under andra kvartalet 2021.
Read MoreVi gratulerar Toleranzia, som idag har gjort listbyte från Spotlight till Nasdaq! Toleranzias aktier och teckningsoptioner av serie TO3 från och med idag handlas på Nasdaq First North Growth Market ("Nasdaq").
Read MoreNorska Teknisk Ukeblad publicerade söndagen den 11 oktober en artikel om SeaTwirl skriven av Thomas Førde. I artikeln beskrivs att SeaTwirl har utvecklat en turbin med vertikal axel som ska testas i havet vid Bokn i Rogaland i 2022.
Read MoreI-Tech AB: s teknik, Selektope®, har valts för att skydda skrovet på Global Mercy, det sjukhusfartyge som nu byggs för Mercy Ships, från havstulpanpåväxt under långa stillaliggande perioder i områden med högt påväxttryck längs med Afrikas kuster.
Read MoreEn forskare vid namn Sumit Kar, PhD som arbetar vid kontraktsforskningsbolaget Celerions laboratorium i USA har erhållit "Best Abstract Award" av American Association of Pharmaceutical Scientists (AAPS). I arbetet kombineras PExAs teknologi med ultrakänsliga analysmetoder för att detektera cytokin-biomarkörer från de nedre luftvägarna.
Read MoreSurgical Science har ingått ett långsiktigt ramavtal med Auris Health Inc., som är en del av Ethicon Inc. inom Johnson & Johnson-koncernen, om samarbete kring utveckling av simulering för robotkirurgi. Avtalet innebär initialt en tillpassningsfas av Surgical Sciences simuleringsmjukvara samt en uppgörelse om royalty i form av en licensavgift för varje framtida robot som innehåller Surgical Sciences mjukvara. Under tillpassningsfasen uppskattas konsultintäkterna till omkring 10 MSEK, totalt under 2020 och 2021. Licensintäkterna förväntas utfalla under lång tid med start vid robotens kommersiella lansering och bli betydande för Surgical Science men går inte att kvantifiera i förväg.
Read MoreCereno Scientific AB (“Cereno” eller “Bolaget”) har genomfört en riktad nyemission av sammanlagt 15 800 000 units med en total emissionslikvid om 60 MSEK. Den riktade nyemissionen har riktats till en begränsad grupp kvalificerade investerare.
Read MoreNasdaq Stockholm AB har idag godkänt Toleranzia AB:s (”Toleranzia” eller ”Bolaget”) ansökan om upptagande till handel av Bolagets aktier och teckningsoptioner av serie TO3 på Nasdaq First North Growth Market (”Nasdaq First North”). Första dag för handel på Nasdaq First North är fastställd till den 15 oktober 2020.
Read MoreCereno Scientific meddelade idag att bolaget kommer att fortsätta utvecklingen av läkemedelskandidaten CS1 som en epigenetisk modulator för sällsynta sjukdomar med särläkemedelspotential. Det inledande fokuset är på sjukdomen pulmonell arteriell hypertension (PAH), en form av högt blodtryck i lungorna. Bolagets reviderade kliniska utvecklingsstrategi för CS1 utformades tillsammans med framstående kommersiella, vetenskapliga och regulatoriska rådgivare i Europa och USA med insikter från amerikanska läkemedelsmyndigheten US FDA. Ett Fas IIa-studieprogram är planerat att starta under första halvåret 2021.
Read MoreMimbly har beviljats ett bidrag på 19 MSEK (1,85 m €) från European Innovation Council ur deras fond på 300 miljoner euro för gröna innovationer. Anslaget bidrar till att kommersialisera Mimblys produkt ‘Mimbox’, som är kompatibel med nya, och befintliga, kommersiella tvättmaskiner. Den patenterade tekniken i Mimboxen återvinner upp till 70% av vattnet, sparar energi och filtrerar bort mikroplast från tvättvattnet när syntetiska tyger tvättas.
Read More